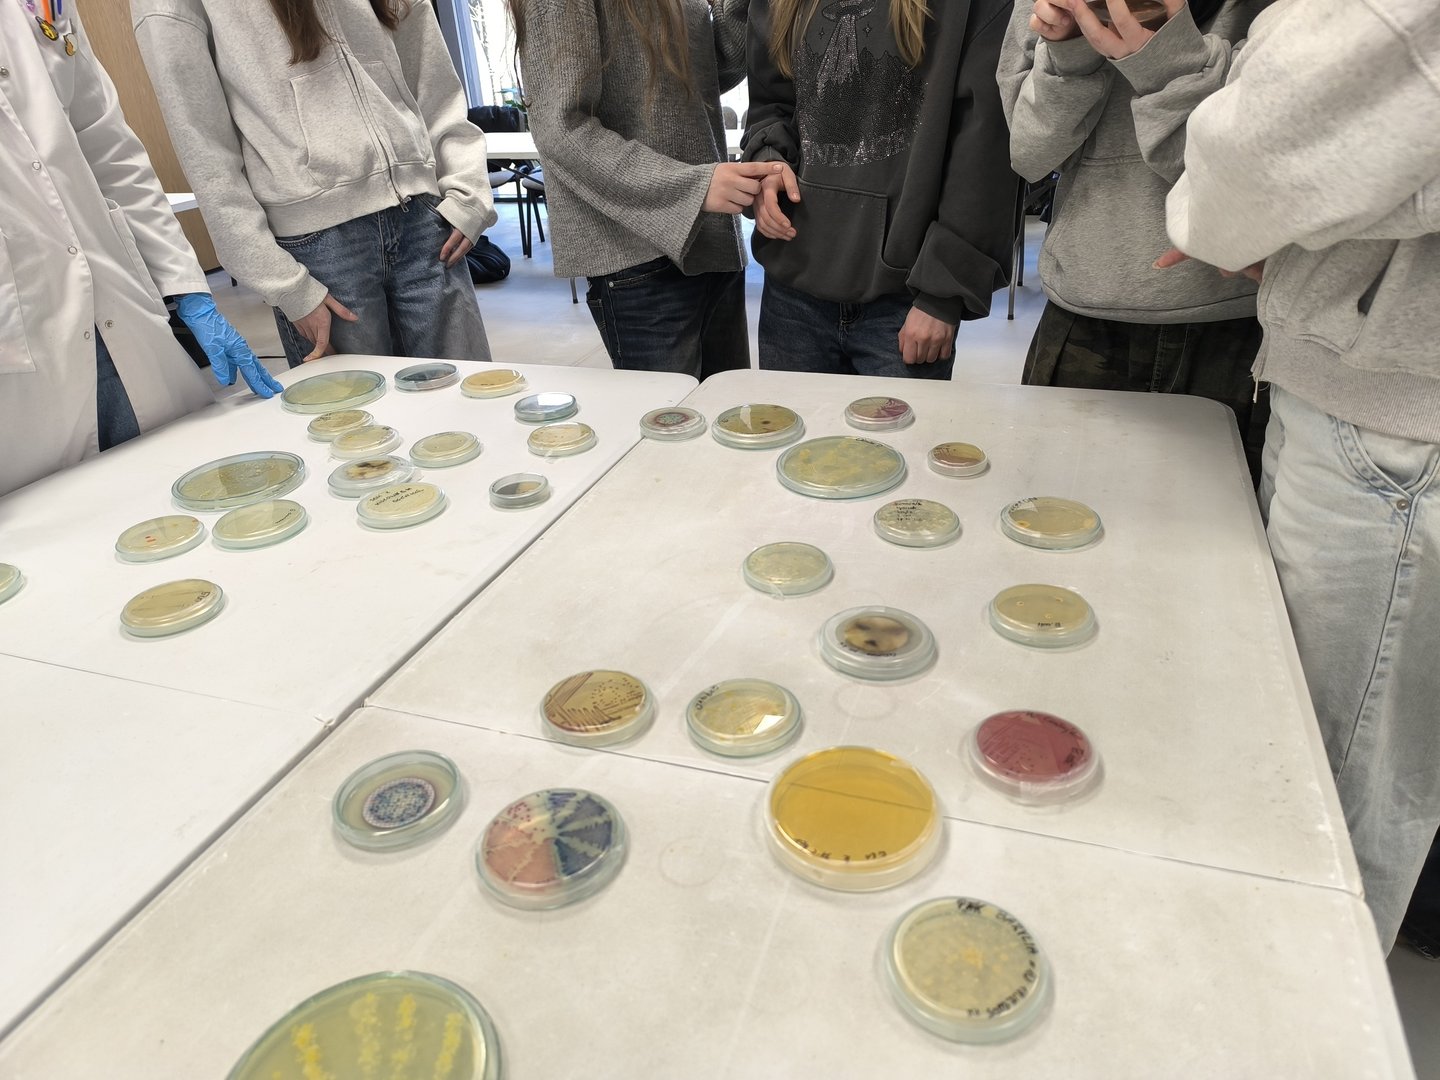
Piknik zoo

During the event, we will discover the fascinating world of microorganisms – those that cannot be seen with the naked eye but are everywhere around us.
You'll get a chance to attend demonstrations of microbial cultivation, observations under a microscope and simple activities that will make everyone – regardless of age – feel like a scientist.
About the project
The project "Microorganisms in the ZOO – Discovering the Invisible Inhabitants" is carried out by researchers and students from the University of Lodz and the University of Zagreb. It assumes regular meetings with organised groups, primarily schools, held at the Zoo Orientarium, as well as science picnics organised at the Orientarium (Zoo Łódź). The meetings will include interactive presentations introducing participants to the topics of microorganisms, their biodiversity, their importance for animals (e.g., bioluminescent bacteria) and environmental protection.

The objective of the project is to increase public awareness of the importance of microorganisms in nature and human life through experiential and interactive education. The project aims to demonstrate that microorganisms – though invisible to the naked eye – play a crucial role in maintaining the balance of ecosystems, the health of animals and humans and environmental processes.
The initiative will involve research on microorganisms inhabiting the zoo environment by collecting samples, culturing them and analysing the results. This will provide valuable data on microbial diversity in public spaces.
Dr Małgorzata Siwińska from the University of Lodz Faculty of Biology and Environmental Protection is the project manager. The project is implemented as part of the Science Hub UniLodz platform.
MORE INFORMATION ABOUT THE PROJECT
Source and photos: dr Małgorzata Siwińska (Department of Biology of Bacteria, Faculty of Biology and Environmental Protection, University of Lodz)
Edit: Mateusz Kowalski (Promotion Centre, Faculty of Biology and Environmental Protection, University of Lodz)
